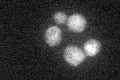
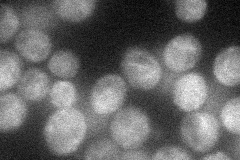
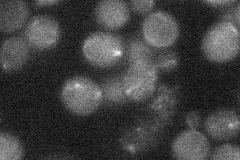
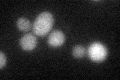

View description
Protein that exhibits physical and genetic interactions with Rpb8p, which is a subunit of RNA polymerases I, II, and III; computational analysis of large-scale protein-protein interaction data suggests a role in chromosome segregation
Localization:
Intensity:
Fold change:
Significance:
-
C’ GFP library in SD
ER25.91 -
N' NOP1pr-GFP in SD
ER38.5399 -
N' TEF2pr-mCherry in SD

ER15.3302 -
N' NATIVEpr-GFP in SD
below threshold18.5602 -
N' TEF2pr-VC and Cyto-VN in SD

below threshold24.6749 -
C’ GFP library in SD+DTT
ER21.460.82No -
C’ GFP library in SD+H2O2

ER27.691.06No -
C’ GFP library in Starvation Media

ER19.780.76Yes -
C’ GFP library on the background of Pup2-DaMP

N/A -
C’ GFP library on the background of CCT mutant

N/A0N/AYes
